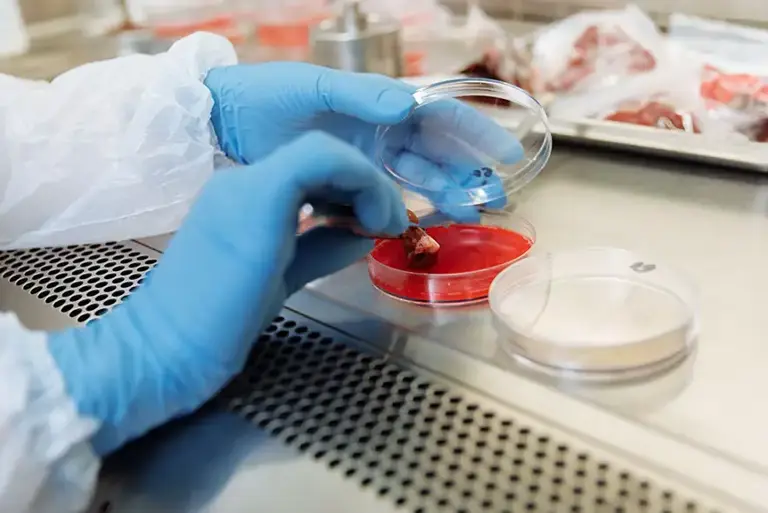
Closeup of the hands of scientists working on animal tissue on a petri dish

Biology

Once a company has chosen which disease area to research, it must be studied so we can understand what the underlying problems are.
This may then allow a discovery team to select a molecular target within a biochemical pathway, such as an enzyme or a receptor, where inhibition or stimulation may lead to changes which result in treatment of the disease.
Once the molecular target, often an enzyme or receptor on a cell membrane, has been identified, it can be used to develop biological tests. These will be used to identify which chemical compounds interact with the target, each one that does is called a ‘hit’.
High throughput screening
This stage of testing is known as "high throughput screening". The protein is added to wells in a plastic plate, compounds that interact with the protein are identified by fluorescence. The whole process is automated so hundreds of thousands of chemical compounds can be tested very quickly. Compounds may come from libraries that the company holds, may be based on existing medicines, or may have been designed to fit the target using computer modelling.
Hits are followed up by making and testing similar molecules, leads, to find the one that has the best chance of becoming a successful medicine. This is known as lead optimisation. Lead compounds are tested in a number of ways to find the one which is likely to have the highest level of activity without dangerous side effects.
A variety of disciplines
A variety of biological experts, working in partnership with chemists and other specialists, will be involved in finding out more about these lead compounds, so that the most promising ones can be selected to take forward into development.
Various disciplines from the biological sciences work in collaboration throughout the drug discovery and development stage, these include pharmacologists working with animal technicians to explore how certain compounds have an effect on tissues.
Other biology specialists are also involved in research. For example immunologists investigate the immunological system, how it is implicated in disease and how it might be manipulated to treat disease. Cell biologists, enzymologists, virologists and microbiologists are also likely to be involved in early research on potential new medicines. The selected compound will be tested for toxicity by researchers working in the drug metabolism and pharmacokinetics (often abbreviated to DMPK) teams.

Research involving animals is vital stage in the development of new drugs.

Treating disease with antibody technology.

Scientists working in drug metabolism and pharmacokinetics (DPMK) will be part of a working team including chemists, pharmacologists and other biological scientists.
A key area within biology is pharmacology. Pharmacologists investigate how potential medicines interact with biological systems.

